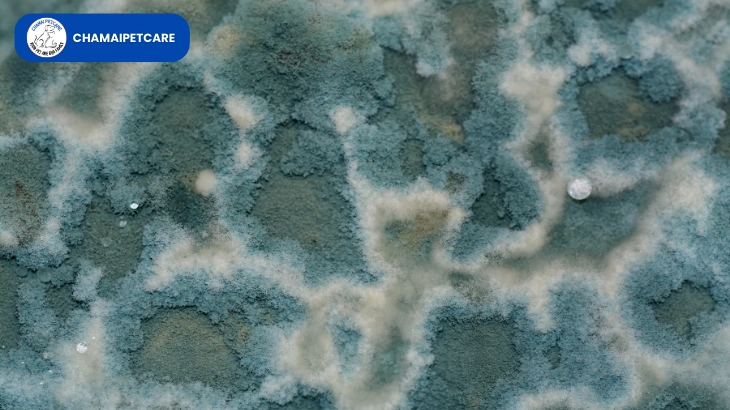

3 วิธีรักษาเชื้อราแมว โรคผิวหนังที่คนรักแมวไม่ควรมองข้าม!

เชื้อราแมว คืออะไร? อาการ วิธีรักษา และป้องกัน ที่เจ้าของต้องรู้!
เชื้อราแมว (Ringworm) เป็นปัญหาผิวหนังที่พบได้บ่อยในกลุ่มสัตว์เลี้ยง โดยเฉพาะแมว ซึ่งไม่เพียงแต่ส่งผลต่อสุขภาพของเจ้าเหมียวเท่านั้น แต่ยังสามารถติดต่อสู่คนได้ บทความนี้คือคู่มือฉบับสมบูรณ์ที่จะช่วยให้คุณเข้าใจและรับมือกับปัญหานี้ได้อย่างถูกวิธี
เชื้อราแมว คืออะไร? ทำไมแมวถึงเป็น?
ทำความรู้จักกับเชื้อราแมว (Dermatophytosis)เชื้อราแมวไม่ได้เกิดจากหนอน (Worm) ตามชื่อภาษาอังกฤษ (Ringworm) แต่เป็นโรคผิวหนังที่เกิดจากเชื้อรากลุ่ม Dermatophytes ซึ่งกินเคราติน (Keratin) ในผิวหนัง ขน และเล็บเป็นอาหาร เชื้อที่เป็นสาเหตุหลักคือ Microsporum canis
ปัจจัยเสี่ยงที่ทำให้แมวติดเชื้อรา
การติดเชื้อเกิดจากการสัมผัสกับสปอร์ของเชื้อรา ซึ่งสามารถอยู่รอดในสภาพแวดล้อมได้นานหลายเดือน แมวที่มีความเสี่ยงสูง ได้แก่:
- ลูกแมวและแมวสูงวัย: ระบบภูมิคุ้มกันยังพัฒนาไม่เต็มที่ หรือเริ่มเสื่อมลง
- แมวที่มีภูมิคุ้มกันต่ำ: เช่น แมวที่เป็นโรคเบาหวาน, FIV, FeLV หรือได้รับยากดภูมิคุ้มกัน
- สภาพแวดล้อม: บริเวณที่มีความชื้นสูง อากาศถ่ายเทไม่ดี หรือมีการเลี้ยงแมวรวมกันจำนวนมาก
- การสัมผัสโดยตรง: การสัมผัสกับสัตว์อื่นหรือสิ่งของ (เช่น กรง, แปรง) ที่ปนเปื้อนเชื้อรา

อาการเชื้อราแมว: สังเกตอย่างไรว่าแมวของคุณติดเชื้อ?
อาการของเชื้อราแมวอาจแตกต่างกันไป แต่สัญญาณที่พบบ่อยและสังเกตได้ง่ายมีดังนี้:
- สัญญาณทางผิวหนังที่ต้องเฝ้าระวัง
- ขนร่วงเป็นหย่อม: เป็นสัญญาณที่ชัดเจนที่สุด มักพบบริเวณใบหน้า หู ขา และหาง ขนร่วงเป็นวงกลมหรือรูปไข่ ขนที่เหลืออยู่บริเวณขอบวงอาจหักง่าย
- ผิวหนังแดง/มีสะเก็ด: บริเวณที่ขนร่วงอาจมีลักษณะแดง แห้ง มีขุยสีขาว/เทาคล้ายรังแค หรือมีสะเก็ดเป็นวง
- ความผิดปกติของเล็บ: เล็บอาจเปราะหรือผิดรูป (พบได้ไม่บ่อยนัก)
- อาการคัน: แมวอาจมีอาการคันหรือไม่ก็ได้ และมักไม่รุนแรงเท่าอาการแพ้จากเห็บหมัด

ข้อควรจำ: หากแมวของคุณมีอาการเหล่านี้ ควรรีบพาไปพบสัตวแพทย์เพื่อวินิจฉัยที่แม่นยำ เพราะอาการของเชื้อราคล้ายกับโรคผิวหนังอื่น ๆ (เช่น ภูมิแพ้)
การวินิจฉัยของสัตวแพทย์สัตวแพทย์จะใช้วิธีการวินิจฉัยที่แตกต่างกัน เช่น:
- ไฟ Wood's Lamp: ส่องไฟพิเศษเพื่อดูว่าบริเวณที่มีเชื้อราเรืองแสงสีเขียวหรือไม่ (แต่ใช้ได้กับเชื้อราบางชนิดเท่านั้น)
- การตรวจด้วยกล้องจุลทรรศน์: ตรวจเส้นขนเพื่อหาโครงสร้างของเชื้อรา
- การเพาะเชื้อรา (Fungal Culture): เป็นวิธีที่แม่นยำที่สุด โดยการนำตัวอย่างขนและสะเก็ดผิวหนังไปเพาะเลี้ยงเพื่อระบุชนิดของเชื้อรา

วิธีรักษาเชื้อราแมว: ต้องทำอย่างไรให้หายขาด?
การรักษาเชื้อราแมวต้องใช้ความอดทนและใช้เวลานาน (46 สัปดาห์หรือนานกว่านั้น) และต้องครอบคลุมทั้งการรักษาตัวแมวและการทำความสะอาดสภาพแวดล้อม
1. การรักษาเฉพาะที่ (Topical Treatment)
ใช้สำหรับควบคุมเชื้อราบนผิวหนังและลดการแพร่กระจาย:
การตัดขน: ตัดขนรอบ ๆ บริเวณที่ติดเชื้อ (หรืออาจต้องตัดทั้งตัวในรายที่เป็นเยอะ) เพื่อให้ยาซึมซับได้ดี
แชมพูฆ่าเชื้อรา: อาบน้ำด้วยแชมพูที่มีส่วนผสมของ Miconazole หรือ Ketoconazole ตามคำแนะนำของสัตวแพทย์
ยาทาเฉพาะจุด: ทาครีมหรือโลชั่นฆ่าเชื้อราตามคำแนะนำ
2. การรักษาด้วยยาแบบกิน (Systemic Treatment)
ใช้ในกรณีที่เชื้อราเป็นบริเวณกว้าง มีอาการรุนแรง หรือการรักษาเฉพาะที่ไม่ได้ผล:
ยาฆ่าเชื้อราชนิดกิน: เช่น Itraconazole หรือ Griseofulvin ยาเหล่านี้จะซึมเข้าสู่ผิวหนังและเส้นขนเพื่อกำจัดเชื้อ
️ข้อควรระวัง: ยาฆ่าเชื้อราชนิดกินต้องได้รับคำแนะนำและควบคุมปริมาณโดยสัตวแพทย์อย่างเคร่งครัด เพราะอาจมีผลต่อตับ โดยเฉพาะในลูกแมว
3. ข้อควรระวังระหว่างการรักษา
ห้ามหยุดยาเอง: ต้องให้การรักษาต่อเนื่องจนกว่าสัตวแพทย์จะยืนยันว่าผลเพาะเชื้อเป็น ลบ 2 ครั้งติดต่อกัน (แม้ว่าอาการภายนอกจะดูดีขึ้นแล้ว)
แยกแมวป่วย: ควรแยกแมวที่ติดเชื้อออกจากสัตว์เลี้ยงตัวอื่นและคนในบ้านเพื่อป้องกันการแพร่กระจาย
3 วิธีรักษาเชื้อราแมว
1.สเปรย์รักษาเชื้อราที่มีส่วนผสมของตัวยา Ketroconazole

ข้อดี:
- ราคาถูก
- หาซื้อได้ง่าย
- ใช้งานง่าย
ข้อเสีย:
- ห้ามแมวเลีย
- ใช้เวลานานที่สุดในการรักษา
- ส่งฤทธิ์ต่อตับรุนแรง
2.แชมพูรักษาเชื้อราที่มีส่วนผสมของตัวยา Miconazole nitrate

ข้อดี:
- ใช้ระยะเวลาไม่นานในการรักษา
- ใช้ได้นาน
ข้อเสีย:
- ใช้งานค่อข้างยากสำหรับแมว
- มีฤทธิ์แรงแมวบางตัวอาจแพ้ได้
- ราคาค่อนข้างสูง
- หาซื้อยาก
3.ยากินรักษาเชื้อราที่มีส่วนผสมของตัวยา Itraconazole

ข้อดี:
- ราคาอยู่ในเกณฑ์ปานกลาง
- หาซื้อได้ง่าย
- ใช้งานง่าย
- ใช้ระยะเวลาไม่นาน
ข้อเสีย:
- ส่งผลต่อตับเล็กน้อย
- ใช้งานยากกับลูกแมวหรือแมวที่น้ำหนักน้อย
เชื้อราแมวติดต่อสู่คนได้หรือไม่?
คำตอบคือ: ได้
เชื้อราแมวเป็นโรคที่ติดต่อระหว่างสัตว์สู่คน (Zoonotic Disease) โดยเชื้อราจะเข้าสู่ผิวหนังของคนผ่านการสัมผัสโดยตรงหรือสัมผัสสิ่งของที่มีสปอร์
- อาการในคน: มักเป็นผื่นวงแหวนสีแดง ขอบนูน มีขุย และมีอาการคัน เรียกว่า "Tinea"
- กลุ่มเสี่ยง: เด็กเล็ก, ผู้สูงอายุ, ผู้ที่มีภูมิคุ้มกันอ่อนแอ (เช่น ผู้ป่วยมะเร็ง, ผู้ที่รับประทานยากดภูมิ) ควรระมัดระวังเป็นพิเศษ
- วิธีทำความสะอาดและฆ่าเชื้อในบ้าน
การควบคุมสิ่งแวดล้อมเป็นหัวใจสำคัญในการกำจัดเชื้อราและป้องกันการกลับมาเป็นซ้ำ:
ทำความสะอาดด้วยน้ำยาฆ่าเชื้อ:
ใช้ น้ำยาฟอกขาว (Bleach) เจือจางในอัตราส่วน 1:10 (น้ำยาฟอกขาว 1 ส่วน ต่อน้ำ 10 ส่วน) เพื่อเช็ดทำความสะอาดพื้นผิวแข็ง เช่น พื้นกระเบื้อง พื้นไม้ โต๊ะ เก้าอี้
จัดการขนและฝุ่น:
ดูดฝุ่นเป็นประจำ: ใช้เครื่องดูดฝุ่นที่มีระบบกรอง HEPA เพื่อดักจับสปอร์ของเชื้อรา (ทิ้งถุง/ทำความสะอาดที่เก็บฝุ่นทันทีหลังใช้)
ซักล้างของใช้:
- ผ้าปูที่นอน, ผ้าห่ม, ที่นอนแมว, ผ้าเช็ดตัว, และของเล่นผ้า ให้ซักด้วย น้ำร้อน และถ้าทำได้ ควรเป่าแห้งด้วยความร้อนสูง
- การป้องกันการกลับมาเป็นซ้ำ
- หมั่นดูแลสุขภาพของแมวให้แข็งแรงด้วยอาหารที่มีคุณภาพ
- ควบคุมความชื้นในบ้าน
- หากมีการรับสัตว์เลี้ยงใหม่ ควรมีการกักโรคและตรวจเชื้อราก่อนนำมารวมกับแมวตัวอื่น
Chamai Petcare


